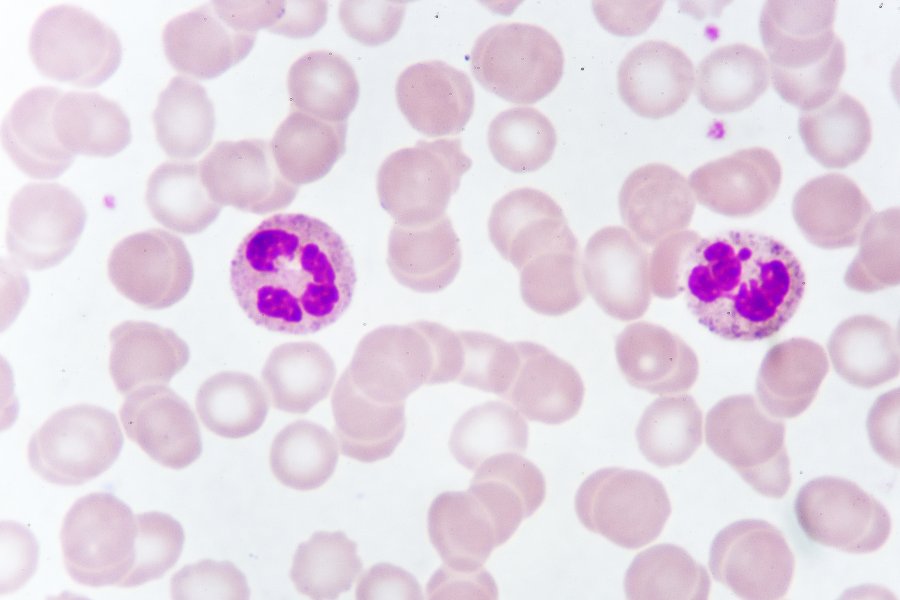
Limfocyty – jaka jest ich rola w organizmie?

- Polecane
- Endokrynologia
- Okulistyka
- Ortopedia
- Stomatologia
- Alergologia
- Kardiologia
- Ginekologia
- Dermatologia
- Neurologia
- Laryngologia
- Urologia
- Pulmonologia
- Diabetologia
- Zdrowie
- Odżywianie i Diety
- Pediatria
- Badania i diagnostyka
- proktologia
- Psychiatria i psychologia
- Reumatologia
- Hematologia
- Onkologia
- Chirurgia
- Czasopismo OSOZ
- Nefrologia
- Gastrologia
- Medycyna estetyczna
Limfocyty – jaka jest ich rola w organizmie? Co oznacza obniżony lub podwyższony poziom limfocytów?
- Publikacja:
- 2021-03-24 12:14
- Aktualizacja:
- 2023-12-06 11:24
Za odporność organizmu odpowiada prawidłowo funkcjonujący układ immunologiczny. Składa się on z wielu elementów, a jednym z nich są limfocyty. Jaką rolę pełnią w organizmie? Na co wskazuje obniżona lub podwyższona ilość limfocytów?
Czym są limfocyty?
Limfocyty należą do grupy krwinek białych (leukocytów) – stanowią 20-40% ogólnej liczby leukocytów. Mają postać kulistych komórek, a w ich wnętrzu znajduje się jądro komórkowe otoczone cytoplazmą. Limfocyty są to niewielkie komórki, rzadko przekraczające 10 µm. Wyróżniamy limfocyty B, T oraz komórki NK.
- Limfocyty B – powstają w szpiku kostnym i również w nim dojrzewają. Odpowiadają za humoralną reakcję odpornościową, polegającą na wytwarzaniu przeciwciał.
- Limfocyty T – powstają w szpiku, ale dojrzewają w grasicy. Są odpowiedzialne za komórkową reakcję immunologiczną.
- NK – komórki Natural Killers wspierają procesy odpowiedzi nieswoistej. Posiadają aktywność cytotoksyczną – podczas kontaktu z nieprawidłową komórką wydzielają substancje powodujące jej śmierć.
W organizmie człowieka najwięcej jest limfocytów T (stanowią 70% wszystkich limfocytów). Limfocyty B oraz komórki NK (ang. Natural Killers) to ok 15%.
Umów się do lekarza rodzinnego
Jaką rolę w organizmie pełnią limfocyty?
Limfocyty odpowiedzialne są za dwa rodzaje reakcji immunologicznej. Pierwszą z nich jest humoralna odpowiedź immunologiczna związana z produkcją przeciwciał. Kolejna to bezpośrednia swoista odpowiedź komórkowa. Obie te reakcje są inicjowane dzięki antygenom – są nimi białka oraz polisacharydy. Limfocyty rozwijają się przez cały okres życia organizmu. Powstają z komórek macierzystych zlokalizowanych w szpiku kostnym. Najważniejszą rolą w organizmie człowieka jest ochrona przed infekcjami. Prawidłowy poziom limfocytów u osób dorosłych to 1000-5000 /μl krwi. Na ilość limfocytów mają wpływ również przyjmowane leki, suplementy, dieta oraz odwodnienie.
Obniżony poziom limfocytów – limfopenia
Jest to zaburzenie w którym liczba limfocytów we krwi obwodowej wynosi poniżej 1000/μl. Stan ten występuje często w wyniku:
- rozwoju infekcji w organizmie (pierwszy etap choroby),
- sytuacjach stresowych,
- AIDS,
- gruźlicy,
- hipermagnezemii,
- mocznicy,
- zespołach popromiennych,
- przy wstrząsie anafilaktycznym.
Obniżony poziom limfocytów może mieć charakter wrodzony lub nabyty. W obu przypadkach dochodzi do zmniejszonej produkcji tych komórek – może być to skutkiem aplazji szpiku kostnego, radio i chemioterapii, chorób nowotworowych, wirusowego zapalenia wątroby. Osoby chorujące na reumatoidalne zapalenie stawów, stwardnienie rozsiane oraz niewydolność wątroby i nerek często borykają się z problem zbyt niskiego poziomu limfocytów. Stan ten jest groźny, gdyż układ odpornościowy jest wówczas bardzo osłabiony (częściej dochodzić może wówczas do rozwoju infekcji).
Podwyższony poziom limfocytów – limfocytoza
Zwiększony poziom limfocytów występuje wówczas gdy w organizmie dochodzi do zakażenia. U dzieci często występuje podczas przebiegu infekcji, natomiast u osób starszych może występować równocześnie z białaczką, chłoniakiem czy przewlekłymi infekcjami bakteryjnymi. Wysoki poziom limfocytów pojawić się może również u osób po przejściu napadu padaczkowego, u kobiet ciężarnych lub po zabiegu chirurgicznym.
Zaburzenia ilości limfocytów
Jeżeli wyniki badań jednoznacznie wskazują na nieprawidłową liczbę limfocytów należy niezwłocznie udać się do lekarza rodzinnego. Ten w razie konieczności skieruje nas do specjalisty chorób krwi – hematologa. Na podstawie rozszerzonej diagnostyki będzie można określić przyczynę złych wyników badań krwi.
Układ immunologiczny jest podstawą do zachowania prawidłowego stanu zdrowia. Odpowiada bowiem za odporność organizmu – bez niej człowiek nie przeżyłby nawet najmniejszej infekcji. W razie wystąpienia jakichkolwiek odchyleń od normy poziomu limfocytów konieczne jest zbadanie przyczyny oraz jej eliminacja celem poprawy parametrów krwi oraz ogólnego stanu zdrowia.
Wizytę u wybranego specjalisty możesz zarezerwować online za pomocą portalu LekarzeBezKolejki.pl.
Autor
Redakcja lekarzebezkolejki.pl - W skład zespołu redakcyjnego portalu LekarzeBezKolejki.pl wchodzą wykwalifikowani farmaceuci. Ich bogate doświadczenie zawodowe i gruntowna wiedza nabyta na studiach farmaceutycznych umożliwiają tworzenie wiarygodnych i rzeczowych tekstów zgodnie z zasadami medycyny opartej na dowodach naukowych (EBM). Treści te są zawsze oparte na solidnych źródłach, takich jak aktualne badania naukowe czy specjalistyczne publikacje. Zespół łączy profesjonalizm z pasją do ciągłego rozwijania się i chęcią dzielenia się wiedzą, co przekłada się na atrakcyjne i wciągające materiały edukacyjne dla użytkowników.














